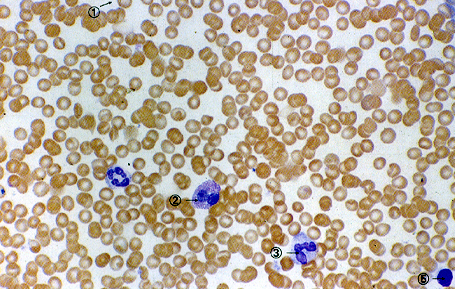
母牛怎么补硒（繁殖母牛怎么补硒）-硒宝网
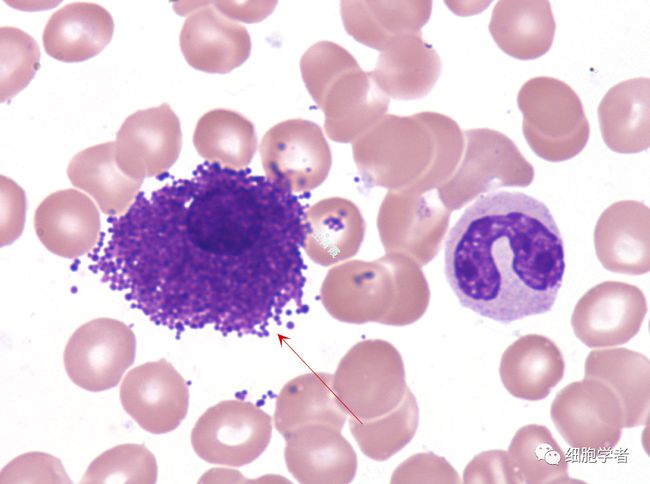
母牛怎么补硒（繁殖母牛怎么补硒）-硒宝网

母牛怎么补硒(繁殖母牛怎么补硒)
维生素E和硒在防御奶牛乳房炎上的作用TF,K88abR和K88acR位点问的连馈检验和重组率估计配对式拴验性别家族数后裔数最大Lod值(Zm)重蛆率性0df注P0。05种现象。重组率与TF—KSgabR—K88acR的次序一致。该次序并不意味着任何双重重组(Doublerecombinations),面政变的投序TF—K88acR—K88abR本应涉及它们中的5种组台。此外,对Ks8abR,K88acR~{K88adR的阳性或阴性表型的不同组台支持K88adR在第三个受体基因控制下的假设。总而言之,TF,K88受体和L血型位点问的连锁与最近的其它研究不相符。如由原位杂交将TF位点定位在第13号染色考系谱的连锁分析将L血型系统定位在第号染色体上(L。Andsrssoa,私人通信’Marklund等,1991)。因此,K88受体位点很可能位于第13号染色体上,因为它们与TF位点连锁本次研究的Lod值很高,而由V6geli等(1992)报道的L血型的连锁只在显着性的边缘处,因面这种连锁必须重新考虑。24(5)l393—396,1993张武学校维生素E和硒在防御奶牛乳房炎上的作用J。S。Hogan维生素E和硒是担负共同生物学活性的必需微量营养成分。
维生素E酶,即谷胱甘肽过氧化物酶(GSH~Px)是许多哺乳动物细胞中存在的抗氧化系统的主要部分。组织硒浓度与GSH—Px的活性有相关性,并直接与目粮的摄入量有关。缺硒土壤上生长的植物不能提供足量的日粮硒来满足奶牛的营养需安。缺硒土壤的地理分布广泛,已知美国约三分之=的奶牛在土壤缺硒地区。奶牛V主要来源是牧草,但是饲料中的a一生育酚浓度随植物成熟而降低饲料加工和贮存时会使V大量减少。奶牛群含饲(不放牧)使饲喂本地生长和贮存的牧草量增多,而这些饲料的V此,在许多奶牛群中日粮Ve和硒缺乏的可能性很大。约十年前首次报道了V和硒缺乏与乳腺健康有联系的直接证据。自首次报道以来,人们运用各种实验模式和设计研究和硒对动物体防御乳房炎方面的作用。最早的试验集中在日粮V和硒缺乏导致临床型乳房炎自然发生率增加方面。此后遍及全世界的田间调查进一步证实H粮中添加Ve和硒对维持奶牛乳腺健康方面的实践意义。实验性攻击和试管内实验最近揭示V和硒涉及动物体非特异性防御的可能作用机理。本文旨在综述有关V,硒与乳腺健康参数之间关系的最新研究。日粮Ve乳晾内感染和临床型乳房炎的发生率近十年问的研究证实乳房炎发生率和严重程度与奶牛群中V和硒状况有关。
给奶牛日粮添加V和硒使临床型乳房炎的发生率减少,持续时间缩短。Smith首次报道了补充Ve和硒对临床型乳房炎作用的对照研究。整个千乳期日粮中每天添加740IUV的乳牛产犊时临床型乳房炎的发生率比饲喂未添~SiiVE『粮的母牛低37%。产犊前21天注射0。1mg硒/kg体重对临床型乳房炎的发生率没有影响。既未又未注射硒的母牛在产犊时乳区感染的百分牢受到了影响。检测和硒对临床体征持续刚问的协同影响。添加V和硒母牛临床体征的持续时间短于添加其中一种的母牛。和硒还影响第一次泌乳母牛产犊时乳腺内感染的发生率。产前60天日粮中每天按每公斤体重补给V21IU:~ll下注射0。1mg硒/kg体重,泌乳期间试验组母牛的添加量为V88IU/kg体重,硒0。3mg/kg体重,对照组初产母牛的产前和泌乳期日粮中不添加V添加组初产母牛乳房内感染的发生率较对照组减少42。泌乳头4天内临床型乳房炎的发生率比对照组减少57。尽管泌乳期间乳腺内感染率没有组问差异,但添加组母牛的乳汁体细胞数比对照组低。有关乳腺健康与V,硒之间联系的田间调查结果表明添加V和硒的益处。Erskin等报道被主要病原感染的乳区百分率与畜群平均全血GsH—Px活性之间呈负相关。

体细胞数高和低的牛群问血清一生育酚的浓度。临床型乳房炎的红细胞GsH—Px活性,乳和血一生育酚浓度均低于未感染群母牛。相反,Ropstad等报道挪威高硒牛群中治疗临床型乳房炎的频率和乳汁体细胞数均临床型乳房炎的发生率以及大容器散装牛乳体细胞数有关血清硒浓度高与临床型乳房炎发生率低,大容器散装牛乳体细胞数低有关。母牛采食的硒不到5mg/d时,血清硒浓度与日粮中的硒浓度呈正相关。超过该水平时血清硒不受硒摄入的影浓度与临床型乳房炎的发生率呈负相关,并且V摄食量对千乳期母牛血清n一生育酚浓度的影响大于泌乳母硒对维持动物体的防御机制具有重要意义,这些机制包括抗体产生,细胞素产生,前列腺素代谢以及嗜中性白细胞功能。许多资料涉及牛的嗜中性白细胞的防御功能。嗜中性白细胞被认为是哺乳动物对细菌感染的主要防御机制。嗜中性自细胞对动物体防御乳腺内感染的重要性已被大贯的资料所证实与乳腺由感染有关的临床型乳房炎发生率和严重程度取决于嗜中性白细胞的应咎能力。因此,使奶牛Vz和硒达摄佳状况的牛群管理实践同样可使嗜中性白细胞的应答达到最佳状态,对乳腺内感染的抵抗力增强。确定V和硒对嗜中性白细胞功能影响的最早试验是在母牛以外的动物上进行的。

Vz或硒缺乏的鼹和人中嗜中性自细胞的杀菌活性降低。嗜中性白细胞引起的呼吸性突变以氧代谢的明显变化为特征,结果导致过氰化物和过氧化氢产物增加。尽管在抗菌防御机制中嗜中性白细胞产生氧代谢产物是必然的,但这些游离基团也会损伤嗜中性白细胞和周围的组织。V和GSH—Px两者都是细胞抗氧化剂,即具有防御氧代谢产物的细胞毒素的能力?;ぷ饔檬窃谙赴誓?。GSH—Px使过氧化氢转变为水,使类脂过氧化氢转变为相应抑制嗜中性白细胞膜上的多聚不饱和脂肪酸的自然氧化。位于细胞膜上与启动游离基团产生的混台功能氧化酶非常接近。通过乳房炎病原菌实验攻击乳区来试验补充硒对嗜中性白细胞对乳腺刺激的反应的功效。Er~kin8等向饲喂补充硒(o。14ppm)或不补充硒(o。04ppm)日粮的牛乳区内灌注埃希氏大肠杆菌攻击后,补硒母牛体细胞反应比未补充母牛体细胞快,每毫升乳汁的菌落形成单位较少,消除乳腺内感较快,临床体征较轻。母牛的硒状况对乳汁嗜中性白细胞在试管内杀死乳房炎病原菌的能力也有影响。同饲喂缺硒日粮的母牛相比,从饲喂补硒丑粮母牛采集的嗜中性白细胞的细胞内杀茼力增强,活力提高,细胞外过氧化氧的浓度降低。肠外性补硒的母牛嗜中性白细胞细胞内杀菌能力也比未补硒母牛的嗜中性白细胞强。
嗜中性白细胞吞噬细菌的能力不受硒的影响。17粮中添加Vn能增强牛血液嗜中性白细胞对金黄色葡萄球菌,埃希氏大肠杆菌的细胞内杀菌能力,但对吞噬指数没有影响。以上结果与日粮中添加Ve增强嗜中性白细胞吞噬作用,降低细胞内杀菌力的报道不同。牛嗜中性白细胞剥V应与对补硒的反应类同。添加Ve和硒对嗜中性白细胞细胞内杀菌能力没有累加于{用。添加V和硒两者对嗜中性白细胞细胞内杀茼能力的影响并不大于单独补充任意一种的结果。然而, Vz 和GSH—Px 能使与细胞内杀菌能力有 关的任何一种物质的需要量减少。由V 产生的细胞膜保护作用可以减少细胞膜上 氧化游离基团对GSH—Px 的需要,从而阻 止游离基团漏入细胞质内,维持该细胞的 细胞内杀茼能力。反之,细胞质内的 GSH—Px 活性可以减少细胞膜对VE 要。Boxer等曾报道类似结果,即V 对保 护GSH—Px 缺乏性人嗜t};性白细胞的抗氧 化损伤作j=I]。 介绍日根的提八量和血液标准日粮 硒的摄入嚣和血硒浓度都可恰当地用来分 析牛群中硒的状况。奶牛丑粮介绍和法定 的硒含量上限为0。3ppm,约相当于荷斯 坦干乳母牛3mg/d,泌乳母牛6mg/d 的摄入量。

现有的少数资料提示,日粮硒 高于0。3ppm能附加地增强机体防御乳房 炎的麓力。然而,肠道内存在一些干扰硒 吸收的因素,如硫酸盐,硝酸盐以及高浓 度的日粮钙。为保证牛群保持适宜的硒状 况,应分析牛群中有代表性母牛纽的血 样。我们建议全血硒浓度至少应为0。2Ixg/ml,但不超过1g/m1,分别相当于 血浆浓度的下限(0。07Ixg/m1)和上限 (0。5g/m1)。 按美国科学院研究理事会制定的干乳 母牛和泌乳母牛对日粮Ve 的需要量为15 IU/kg(干物质摄入量),分别与干乳 母牛和泌乳母牛每天采食VE150IU 和300 IU 相当。这种日粮Ve 浓度能够预防诸如 肌营养不良那样的Ve 缺乏的明显俸征。 但要对乳腺健康产生有益影响必须保证较 高的Ve 摄食量。我们建议干乳母牛和泌 乳母牛两者的Ve 摄入量为1000IU/d,其 理由当母牛的Ve 摄入量添加到该水平时 乳腺内感染,临床型乳房炎和乳汁体细胞 明显降低。根据牧草质量和干物质的摄入 量对饲喂贮存牧草的母??赡苄杼砑覸e 1000IU/d(干乳母牛)和500IU/d(泌 乳母牛)根据嗜中性白细胞的细胞内杀 菌能力与血浆V 浓度之间的关系证明d 认为是适宜的。
肠外性给予V 围产期就像讨论的那样,日粮和血 V,硒的建议浓度与维持机体防御力免 受感染有关。在分娩期那样的应激期间血 液抗氧化物的最佳浓度可能较高。当乳腺 内感染率最高以及围产期嗜中性白细胞功 能降低时,干乳母牛的血浆V 浓度寻常 地低。围产期血浆a 一生育酚的减少与Ve 摄食的变化以及血浆V 转运能力降低有 关。即使在围产期给母牛提供的日粮V 恒定不变,产前7 一lo 天血浆a 一生育酚浓 度仍明显降低,泌乳第2—3 周保持低水 平。除饲料外给妊娠后期母牛应用V 检验其预肪血浆V浓度降低的效果。肠 外性给予Ve 成功地提高了妊娠后期和泌 乳早期血浆和嗜中性自细胞中a 一生育酚浓 周,注射Ve 的母牛血浆d 一生育酚浓度高于注射安 慰剂的母牛。注射Vz 性白细胞的细胞内杀菌能力大于注射安慰的母牛。注射V 或注射安慰剂的母牛之间 嗜中性自细胞的吞噬指数和吞噬率都一 样。干乳期日粮Ve 胞功能的影响小于肠外性给予Ve。围产期母牛嗜中性白细胞功能减弱 已有详尽的记载。据报道,产后1 牛嗜中性白细胞杀菌机制减弱以及与膜相关的化学促进和吸收活性均减弱。尤其是 与新陈代谢的氧化性爆发有关的嗜中性白 细胞功能发生改变。
嗜中性白细胞的这些 功能减弱与Ve 缺乏动物嗜中性自细胞活 性降低类同?;竦肰 注射剂的母牛保持 了血液嗜中性自细胞的细胞内杀菌能力和 嗜中性白细胞的V 浓度。大约在产前10 天皮下注射V否定了产犊时嗜中性白 细胞在休外对埃希氏大肠杆菌细胞内杀菌 作用受到抑制的观点。从产犊到泌乳第4 周,处理母牛血液嗜中性自细胞细胞内杀 菌能力保持不变。产犊时注射安慰剂母牛 的嗜中性白细胞的细胞内杀菌能力低于产 周的水平。已知影响体内嗜中性白细胞功能的一个生理参数是血浆可的松 浓度。产犊时血液皮质类固醇增加产生于 嗜中性白细胞活性的变化之前,注射外源
